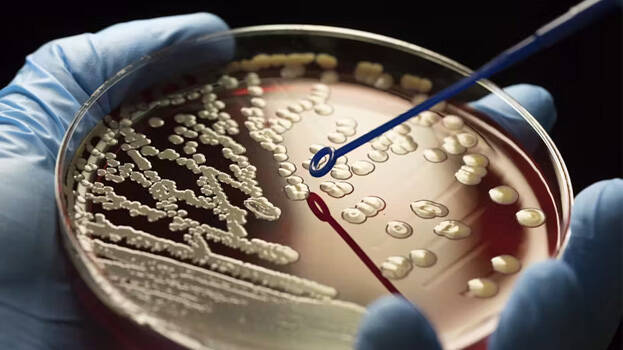
4 4
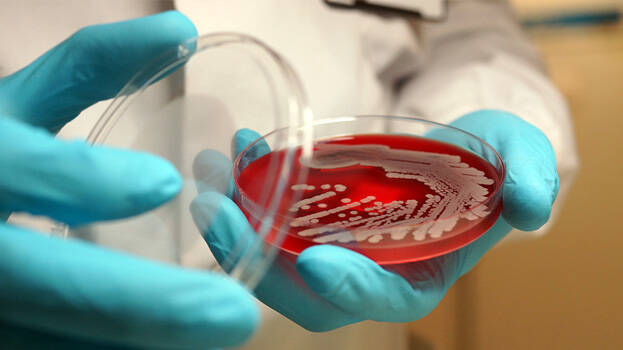
2 2

രോഗം വന്നാൽ മരുന്ന് കഴിച്ച് ചികിത്സിച്ച് ഭേദമാക്കാനാണ് എല്ലാവരും ശ്രമിക്കുന്നത്. എന്നാൽ, മരുന്ന് കഴിച്ചിട്ടും രോഗം തെല്ലും മാറുന്നില്ലെങ്കിലോ? ഇങ്ങനെയുള്ള അവസ്ഥ മനുഷ്യരിൽ ഉണ്ടാകാറുണ്ട്. അതിന് കാരണം ആന്റിബയോട്ടിക് മരുന്നുകളെ പ്രതിരോധിക്കുന്ന സൂപ്പർബഗ്ഗുകളാണ്. ഇത് നമ്മുടെ ശരീരത്തിൽ പ്രവേശിച്ചുകഴിഞ്ഞാൽ മരണത്തിലേക്കുപോലും നയിക്കുന്നു. ഇത്തരത്തിലുള്ള സൂപ്പർബഗ്ഗുകൾ വരുന്ന 25 വർഷത്തിനുള്ളിൽ ഏകദേശം 40 ദശലക്ഷം ആളുകളുടെ മരണത്തിന് കാരണമാകുമെന്നാണ് ഇപ്പോൾ പുറത്തുവന്നിരിക്കുന്ന റിപ്പോർട്ട്.
പ്രതിരോധ കുത്തിവയ്പ്പിന്റെയും ശുചിത്വത്തിന്റെയും പുരോഗതി കാരണം വളരെ ചെറിയ കുട്ടികളിൽ മരണനിരക്ക് കുറഞ്ഞുവരികയാണ്. എന്നാൽ, മുതിർന്നവരിൽ ഇത് വിപരീതമാണെന്നും പഠനത്തിൽ കണ്ടെത്തിയിട്ടുണ്ട്. പുതിയ കണ്ടെത്തലിന് പിന്നാലെ സൂപ്പർബഗുകളുടെ ആഘാതം കുറച്ച് മരണത്തിൽ നിന്നും രോഗിയെ രക്ഷപ്പെടുത്താൻ എന്തെല്ലാം ചെയ്യാം എന്ന ഗവേഷണം ആരംഭിച്ചിട്ടുണ്ട്.
എന്താണ് ആന്റിമൈക്രോബിയൽ പ്രതിരോധം ( എഎംആർ)
രോഗകാരികളായ ബാക്ടീരിയകൾ, വൈറസുകൾ, ഫംഗസുകൾ തുടങ്ങിയവ ഉണ്ടാക്കുന്ന അസുഖങ്ങൾ ചികിത്സിച്ച് മാറ്റാനായാണ് നമ്മൾ ആന്റി ബയോട്ടിക്ക് മരുന്നുകൾ ഉപയോഗിക്കുന്നത്. ഈ മരുന്നുകളെ ശരീരം പ്രതിരോധിക്കും. അതിലൂടെ അസുഖം മൂർദ്ധന്യാവസ്ഥയിൽ എത്തുകയും രോഗി മരണപ്പെടുകയും ചെയ്യുന്നു. ഇങ്ങനെ ആന്റി ബയോട്ടിക്കുകളെ പ്രതിരോധിക്കുന്നത് "സൂപ്പർബഗ്ഗുകൾ" ആണ്. ഇത് ബാക്ടീരിയകൾ, വൈറസുകൾ, ഫംഗസുകൾ തുടങ്ങി എന്തുമാകാം.

അമിതമായും അനാവശ്യമായും ആന്റിബയോട്ടിക്കുകൾ കഴിക്കുന്നവരുടെ ശരീരത്തിലാണ് ഇത്തരത്തിലുള്ള സൂപ്പർബഗ്ഗുകൾ ഉണ്ടാവുന്നത്. കാരണം ശരീരത്തിൽ ആന്റിബയോട്ടിക്കുകൾ നിരന്തരം എത്തുമ്പോൾ അതിനെ ചെറുക്കാനുള്ള പ്രതിരോധ മാർഗം ക്രമേണ നമ്മുടെ ശരീരം സ്വീകരിക്കുന്നു. ഇതോടെ എത്ര വലിയ അളവിൽ ആന്റിബയോട്ടിക്കുകൾ ഉപയോഗിച്ചാലും നമ്മുടെ ശരീരം അതിനെ പ്രതിരോധിക്കുന്ന അവസ്ഥയിലേക്ക് എത്തുന്നു.
പ്രശ്നം ഗുരുതരം
ഗ്ലോബൽ റിസർച്ച് ഓൺ ആന്റി മൈക്രോബിയൽ റെസിസ്റ്റൻസ് (GRAM) പ്രോജക്ടാണ് പുതിയ പഠന റിപ്പോർട്ട് ലാൻസെറ്റ് എന്ന ആഴ്ചപ്പതിപ്പിലൂടെ പ്രസിദ്ധീകരിച്ചത്. 204 രാജ്യങ്ങളിൽ നിന്നും 520 ദശലക്ഷം ജനങ്ങളുടെ രേഖകൾ പരിശോധിച്ച ശേഷമാണ് ഇവർ റിപ്പോർട്ട് തയ്യാറാക്കിയത്. 1990 മുതൽ 2021 വരെയുള്ള മരണസംഖ്യകളും കണക്കിലെടുത്താണ് 2050നുള്ളിൽ സൂപ്പർബഗ്ഗുകൾ കാരണം എത്രപേർ മരണപ്പെടും എന്ന കണക്കുകൾ അവർ പ്രവചിച്ചത്. 22 രോഗാണുക്കൾ, 84 തരം മരുന്നുകൾ, മെനിഞ്ചൈറ്റിസ് പോലുള്ള 11 തരം പകരുന്ന രോഗങ്ങൾ എന്നിവയും പരിശോധിച്ചു.
അടിക്കടി ഉയരുന്ന മരണനിരക്ക്
1990നും 2021നും മദ്ധ്യേ ദശലക്ഷക്കണക്കിന് ജനങ്ങളാണ് സൂപ്പർബഗ്ഗുകൾ കാരണം മരണപ്പെട്ടത്. കഴിഞ്ഞ മൂന്ന് പതിറ്റാണ്ടുകളായി അഞ്ച് വയസിന് താഴെയുള്ള കുട്ടികളിൽ സൂപ്പർബഗ്ഗുകൾ കാരണമുണ്ടാകുന്ന മരണനിരക്ക് 50 ശതമാനത്തിലധികം കുറഞ്ഞിട്ടുണ്ട്. ശിശുക്കളിൽ രോഗപ്രതിരോധ ശേഷി വർദ്ധിപ്പിക്കാനുള്ള കുത്തിവയ്പ്പുകൾ ഫലം കണ്ടുതുടങ്ങിയതായാണ് പഠനത്തിൽ പറയുന്നത്. എന്നിരുന്നാലും കുട്ടികളുടെ ശരീരത്തിൽ സൂപ്പർബഗ്ഗുകൾ എത്തിക്കഴിഞ്ഞാൽ, പിന്നീടുണ്ടാകുന്ന രോഗങ്ങൾ ചികിത്സിച്ച് ഭേദമാക്കാൻ വളരെയധികം ബുദ്ധിമുട്ടാണ്.
70 വയസ് കഴിഞ്ഞവരിൽ സൂപ്പർബഗ്ഗുകൾ കാരണമുണ്ടാകുന്ന മരണം 80 ശതമാനത്തിലധികം വർദ്ധിച്ചു. 2019നെ അപേക്ഷിച്ച് 2021ൽ മരണനിരക്ക് കുറവാണ്. കൊവിഡ് കാലത്തുണ്ടായ നിയന്ത്രണങ്ങളും നടപടികളും കാരണമുണ്ടായ താൽക്കാലിക മാറ്റമാണിതെന്നും ഗവേഷകർ അഭിപ്രായപ്പെടുന്നുണ്ട്.
ആഗോള ഭീഷണി
പഠനത്തിൽ പറയുന്നതനുസരിച്ച് വരുന്ന 25 വർഷം സൂപ്പർബഗ്ഗുകൾ കാരണമുണ്ടാകുന്ന മരണനിരക്ക് കുത്തനെ ഉയരും. റിപ്പോർട്ടിൽ പറയുന്നത് പ്രകാരം സബ്-സഹാറൻ ആഫ്രിക്ക, ഏഷ്യയുടെ തെക്കും കിഴക്കും, ബംഗ്ലാദേശ്, ഇന്ത്യ, പാകിസ്ഥാൻ എന്നിവ ഉൾപ്പെടെയുള്ള ദക്ഷിണേഷ്യൻ രാജ്യങ്ങളിലുള്ള ജനങ്ങളെയാവും സൂപ്പർബഗ്ഗുകൾ ബാധിക്കുക. രോഗങ്ങൾ വരുമ്പോൾ ശരിയായി ചികിത്സ തേടിയാൽ 2050ഓടെ ദശലക്ഷക്കണക്കിന് ജനങ്ങളുടെ ജീവൻ രക്ഷിക്കാൻ സാധിക്കും.